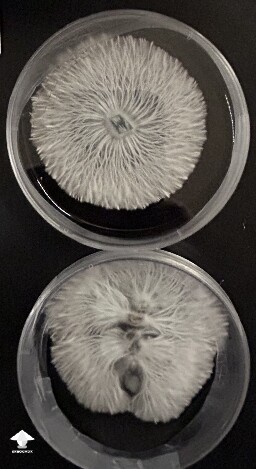
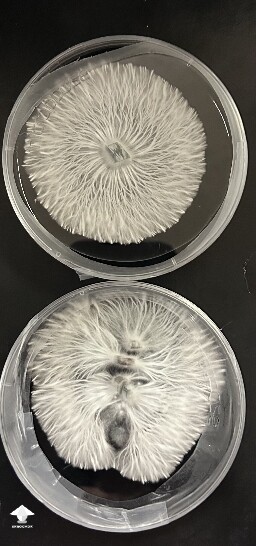
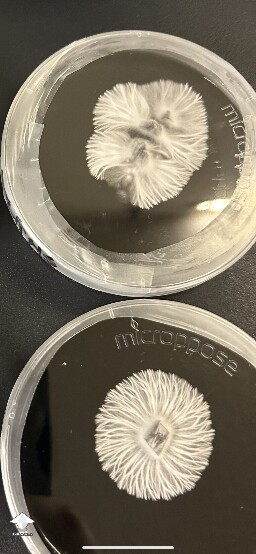

Agar gallery on Shroomok
Photo collection dedicated to mycology on agar. Agar recipes, tips and tricks for agar work, tomentose and rhizomorphic mycelium growth, selection, Agar to Agar transfer, strain isolation, monoculture, contamination on agar and how to deal with it
Shroomok's choice on Amazon

Load more photos